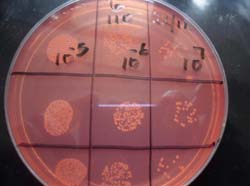

|
I did my MSc in Sustainable Soil Resource Management sponsored by N2Africa. After successfully following one year of course work I worked closely with Dr Paul Woomer in data collection, analysis and thesis writing. Paul became a personal friend who I will never forget. Under the supervision of Dr Paul Woomer, Prof Keya and Prof Nancy Karanja (University of Nairobi) I conducted research on Quality Control of Legumes Inoculant on Bean and Soyabean in East and Central Africa at the MIRCEN lab, University of Nairobi. On the photo from left to right: Prof Shellemiah Keya, the university supervisor, Isaac Balume, Dr Kironji, chairman of LATMAT Department Faculty of Agriculture /University of Nairobi |
![]() |
I hope to publish two papers from his thesis: the first is under review for the journal "Applied and Environmental Microbiology".
In May 2013 I presented my draft paper at a "writeshop" at Wageningen University in The Netherlands. I really appreciated this good opportunity to exchange knowledge and experiences with Prof. Ken Giller, Dr Linus Franke, Dr Jeroen Huising and Judith de Wolf and get support during the writing process. Since completing my MSc work I have continued rhizobiology activities within the N2Africa program at Kalambo research station, DRC for four months, where I have established quality control procedures in DRC, ensured proper storage of the NAC rhizobia collection, started early greenhouse screening of rhizobia using common bean as the host plant and secured the Walungu peat deposit for further inoculant production in the region.
Overall 107 isolates from Bintu collection were re-isolated and characterized in YEMA Congo red and BTB before to be assigned the NAC code N2AFRICA Congo. Over 500 packets on soyabean and 250 packets on common bean rhizobium inoculant using Walungu peat standards strains (USDA 110, SEMIA 5019, USDA 2667 and 422) were produced at Kalambo for this long rain season. National partners DIOBASS, PAD and SARCAF in partnership with the DFID project from the Wageningen University received inoculant for farmers training and input distribution. Quality control assessment was set in the objective of giving high quality product to farmers at least 109 cells g-1 of inoculant.
![]() |
Left: Serial dilution and plating Right: Rhizobium colonies on Yeast-mannitol agar containing Congo Red
|
![]() |
I express my gratitude to the whole N2Africa team and hope to continue work for the benefit of smallholder farmers in Africa.
Isaac Balume